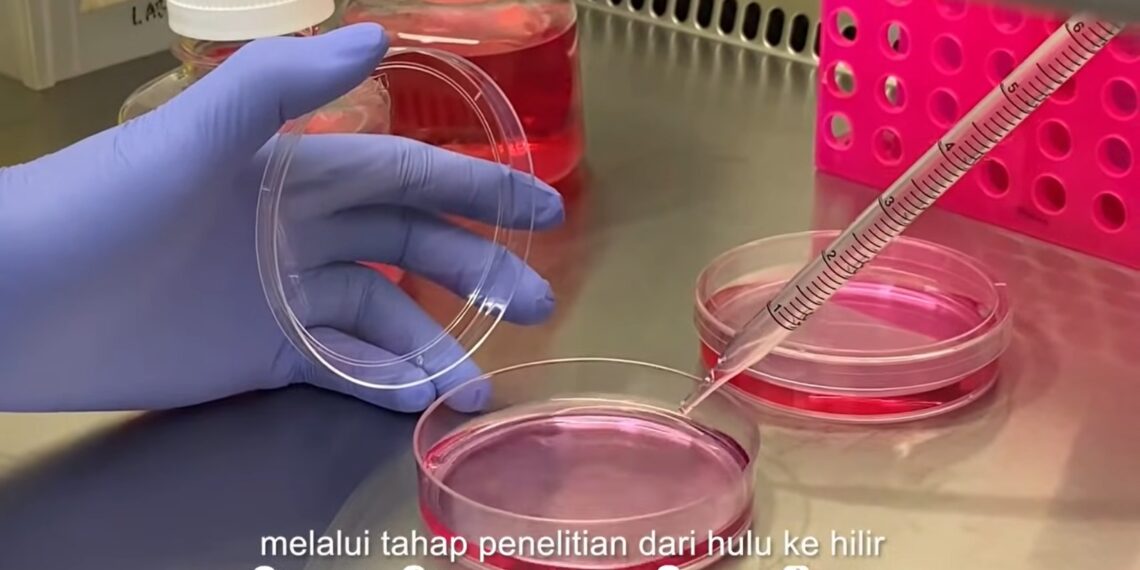
Dies Natalis Ke-63 UB Dorong Jamu Modern Berbasis Riset Terukur

Kanal24, Malang – Universitas Brawijaya (UB) terus meneguhkan perannya sebagai perguruan tinggi yang mendorong riset agar berdampak nyata bagi masyarakat. Di tengah kekayaan hayati Indonesia dan tradisi jamu yang telah mengakar kuat, UB melihat pentingnya menghadirkan inovasi berbasis sains untuk menjawab tantangan kesehatan modern sekaligus meningkatkan daya saing produk herbal nasional. Komitmen tersebut ditunjukkan melalui penguatan hilirisasi riset yang menghubungkan hasil penelitian dengan kebutuhan publik.
Sidang Pleno Terbuka Majelis Wali Amanat Universitas Brawijaya digelar pada Senin (05/01/2026), di Gedung Samantha Krida Universitas Brawijaya. Kegiatan ini diselenggarakan oleh Universitas Brawijaya sebagai bagian dari rangkaian peringatan Dies Natalis, sekaligus menjadi momentum peluncuran produk inovasi hasil riset Pusat Inovasi Jamu dan Biofarmaka UB yang dipimpin oleh Prof. Dr. Ir. Moch. Sasmito Djati, M.S., IPU., ASEAN Eng.
Baca juga:
Membaca Politik dengan Pendekatan Kritis dan Kreatif

Peran Sains dalam Jamu Modern
Prof. Moch. Sasmito Djati menegaskan bahwa Indonesia memiliki kekayaan tanaman obat dan kearifan lokal jamu yang luar biasa. Tantangan utamanya adalah bagaimana mengembangkan potensi tersebut agar dapat diterima secara luas melalui pendekatan ilmiah yang terukur.
“Kemajuan bioinformatika dan riset bioaktif memungkinkan senyawa dalam tanaman herbal dipetakan secara sistematis, mulai dari target biologis hingga mekanisme kerjanya,” ungkapnya.
Melalui rangkaian penelitian in vitro, in vivo, dan in silico, Pusat Inovasi Jamu dan Biofarmaka UB menguji setiap bahan herbal serta kombinasinya. Pendekatan ini menjadikan produk jamu tidak lagi sekadar tradisional, tetapi berbasis kajian ilmiah yang dapat dipertanggungjawabkan dan dikembangkan dari hulu ke hilir.
Peluncuran BX Slim dan MHB
Pada kesempatan tersebut, UB memperkenalkan dua produk herbal inovatif, yakni BX Slim dan MHB. BX Slim dirancang untuk membantu mendukung pengendalian lemak tubuh sebagai bagian dari gaya hidup sehat dan seimbang. Sementara itu, MHB dikembangkan untuk membantu meringankan gangguan lambung yang kerap dikenal masyarakat sebagai masalah asam lambung.
Kedua produk ini menjadi simbol komitmen UB dalam mengangkat kekayaan herbal Nusantara menjadi solusi kesehatan modern yang aman dan bertanggung jawab. Produk-produk tersebut juga dibagikan kepada civitas akademika yang hadir sebagai bentuk pengenalan langsung hasil inovasi universitas.
Maja Matara dan Industri Budaya
Selain produk kesehatan, UB juga meluncurkan inovasi ketiga bertajuk Maja Matara, sebuah produk parfum berkarakter natural dengan sentuhan aroma elegan. Maja Matara lahir dari riset interdisipliner yang mentransformasikan narasi budaya Nusantara menjadi inovasi produk presisi berbasis bahan alami berkualitas.
Terinspirasi dari warisan peradaban Nusantara, mulai dari Medang Mataram hingga kejayaan Majapahit, Maja Matara tidak hanya diposisikan sebagai produk wewangian, tetapi juga sebagai representasi Brawijayan Spiritākecerdasan yang berakar pada budaya dan siap bersaing di tingkat global.
Inovasi sebagai Diplomasi Budaya
Peluncuran ketiga produk ini juga dipandang sebagai bagian dari strategi diplomasi budaya. Melalui pendekatan cultural industry dan semangat globalizing Brawijayan value, UB percaya bahwa warisan budaya tidak cukup hanya diingat, tetapi harus dihadirkan dan dirasakan. Produk inovasi diposisikan sebagai instrumen untuk membawa jiwa dan keindahan Nusantara ke kancah dunia.
Universitas Brawijaya berharap kehadiran BX Slim, MHB, dan Maja Matara menjadi langkah strategis dalam memperkuat hilirisasi inovasi universitas. Dengan dukungan seluruh pihak yang terlibat dalam penelitian, pengembangan, dan hilirisasi, UB optimistis produk herbal dan biofarmaka nasional mampu melesat dan memberikan manfaat nyata bagi masyarakat luas. (nid)